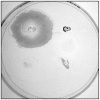
Figure 6

Deciphering the multifactorial nature of Acinetobacter baumannii pathogenicity
- PMID: 21829642
- PMCID: PMC3148234
- DOI: 10.1371/journal.pone.0022674
Deciphering the multifactorial nature of Acinetobacter baumannii pathogenicity
Abstract
Background: Acinetobacter baumannii is an emerging bacterial pathogen that causes a broad array of infections, particularly in hospitalized patients. Many studies have focused on the epidemiology and antibiotic resistance of A. baumannii, but little is currently known with respect to its virulence potential.
Methodology/principal findings: The aim of this work was to analyze a number of virulence-related traits of four A. baumannii strains of different origin and clinical impact for which complete genome sequences were available, in order to tentatively identify novel determinants of A. baumannii pathogenicity. Clinical strains showed comparable virulence in the Galleria mellonella model of infection, irrespective of their status as outbreak or sporadic strains, whereas a non-human isolate was avirulent. A combined approach of genomic and phenotypic analyses led to the identification of several virulence factors, including exoproducts with hemolytic, phospholipase, protease and iron-chelating activities, as well as a number of multifactorial phenotypes, such as biofilm formation, surface motility and stress resistance, which were differentially expressed and could play a role in A. baumannii pathogenicity.
Conclusion/significance: This work provides evidence of the multifactorial nature of A. baumannii virulence. While A. baumannii clinical isolates could represent a selected population of strains adapted to infect the human host, subpopulations of highly genotypically and phenotypically diverse A. baumannii strains may exist outside the hospital environment, whose relevance and distribution deserve further investigation.
Conflict of interest statement
Figures

References
-
- Dijkshoorn L, Nemec A, Seifert H. An increasing threat in hospitals: multidrug-resistant Acinetobacter baumannii. Nat Rev Microbiol. 2007;5:939–951. - PubMed
-
- Joly-Guillou ML. Clinical impact and pathogenicity of Acinetobacter. Clin Microbiol Infect. 2005;11:868–873. - PubMed
-
- Imperi F, Antunes LCS, Blom J, Villa L, Iacono M, et al. The genomics of Acinetobacter baumannii: insights into genome plasticity, antimicrobial resistance and pathogenicity. IUBMB Life. 2011;63:xxx–xxx (in press). - PubMed
Publication types
MeSH terms
Substances
LinkOut - more resources
Full Text Sources
Molecular Biology Databases

